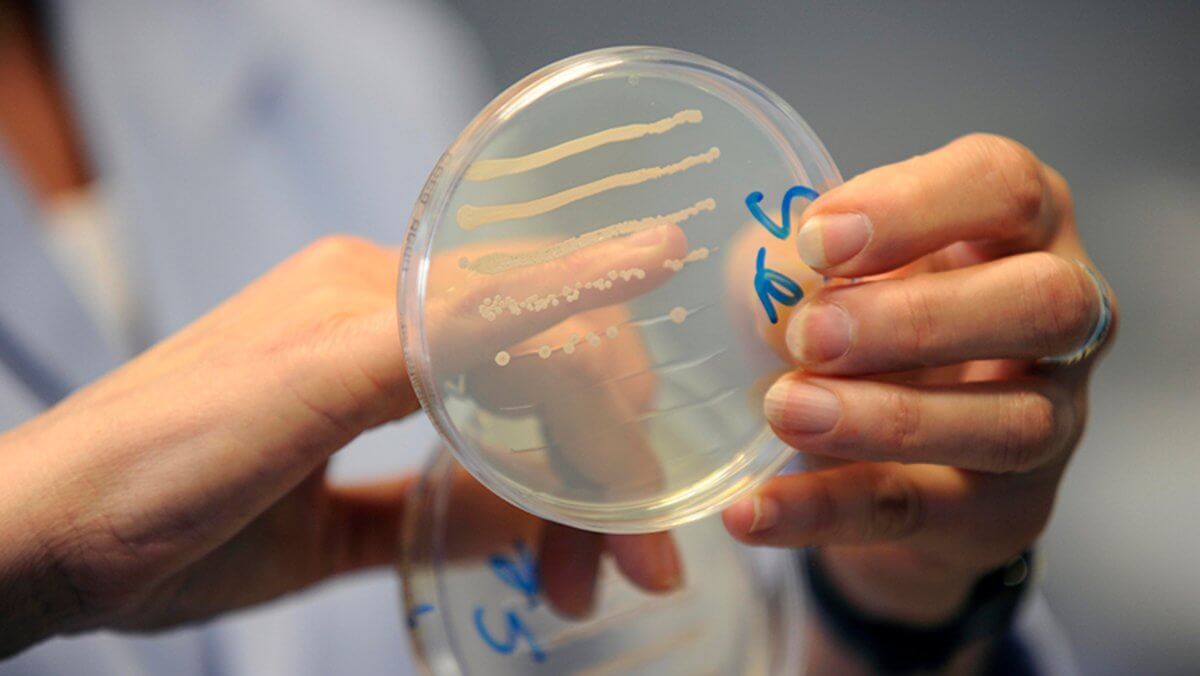

Жапонияда адам өміріне қауіпті аурулардың бірі – гемолитикалық стрептококк ауруы тез тарап жатыр. Ол – ангинаны жиі қоздыратын тамақ ауруы.
NHK телеарнасының мәліметінше, 5 мамырдан бері елде індетті 801 адам жұқтырған. Бұл – өткен жылдың сәйкес кезеңімен салыстырғанда 2,76 есе көп.
2023 жылы жалпы 941 жедел гемолитикалық стрептококк инфекциясы тіркелген.
Мамандардың айтуынша, аурудың тез таралуы коронавирусқа қарсы қорғаныс шараларының азаюымен байланысты болуы мүмкін.